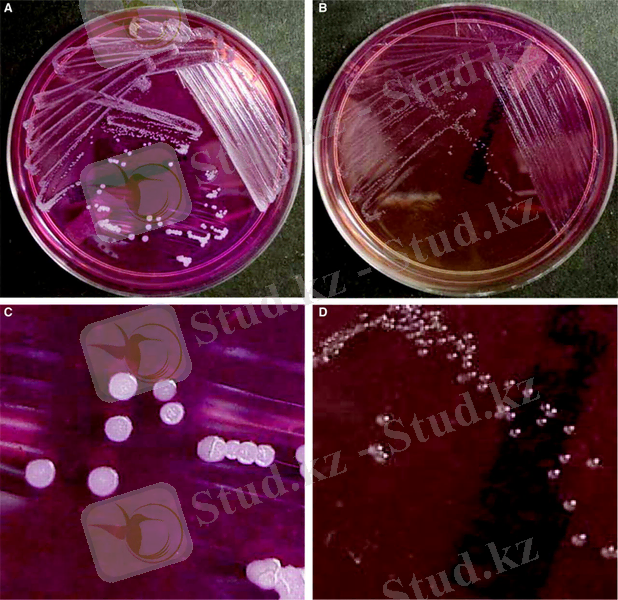
C:\Users\User\Desktop\жука\F1.large.jpg

Маңқа ауруы: қоздырғышы, клиникалық-патологиялық ерекшеліктері және алдын алу мен жою шаралары


Реферат
Тақырыбы: «Маңқа қоздырушысы»
Алматы, 2014 ж
Жоспар: I Кіріспе 3 II Негізгі бөлім:а) Маңқа ауруының қоздырушысы 4
б) Аурудың шығуы мен жұғуы 7
в ) Сауықтыру шаралары және індет ошағын жою 11
г) Биологиялық қару 15
III Қорытынды 18 IV Пайдаланылған әдебиеттер 19Кіріспе
Адамзат ерте заманнан бері мал мен адам арасында жоғары өнім тудыратын жаппай аурулардың себебін анықтауға тырысты.
Жұқпалы ауруларды зерттеу адамзаттың өркендеуінде ұзақ мерзімді орын алады. Жұқпалы ауруларды болдырмау үшін оның таралуын, қоздырғышын, клиникалық белгілерін, эпизоотологиялық мәліметтерін, аурудың дамуын, өлексенің патолого - анатомиялық өзгерістерін, диагностикалық және дифференциальды балауын, иммунитетін және емдеу әдістерін, алдын алу және күресу шараларын білу керек.
Жұқпалы аурулардың өзінің табиғатына қарай жұқпалы емес аурудан кәдімгідей айырмашылығы бар, сондықтан жануарлар патологиясында ерекше орын алады.
Малдың жұқпалы аурулары туралы ғылым ветеринарияда өзекті мәселе және арнаулы бағыт болып табылады.
Мал басын көбейту, оның өнімділігін арттыру және интенсификациялау - мал шаруашылығында негізгі бағыт болып белгіленген.
Осыған байланысты, еліміздің ветеринарлық қызметінің міндеті - малдың және құстың өлімін және ауруын төмендету үшін, ветеринарлық - санитарлық шаралардың жүйесін іске асыру болып табылады.
Нақты жұқпалы ауру кезіндегі індет процесін зерттегенде, оның биологиялық құбылыстармен ғана емес, табиғи - географиялық, әлеуметтік - экономикалық жағдайлармен де байланысты екенін ескеру қажет.
Сондықтан да, жұқпалы ауруларды зерттегенде басқа да ғылымдардың үрдістері мен әдістерін кеңінен пайдаланады.
Ауыл шаруашылығы малдарының жұқпалы ауруларымен күресудің басты шаралары жоспарлы түрде жүргізілгенде ғана, оның тиімділігін арттыруға болады.
Ауыл щаруашылығында жануарларды шыңынға үшырататын жұқпалы аурудың бірі- Маңқа ауруы. Маңқа- созылмалы өтетін, негізінен өкпенің, танау қуысы кілегейлі қабығының және терінің ерекше қабынуымен білінетін инфекциялық ауру. Табиғи жағдайда ауруға жылқы, қашыр, есек, пони, сирегірек түйе шалдығады.
Негізгі бөлім
Маңқа ауруының қоздырушысы. Маңқа (Malleus, сап) - жылқының есек пен қашырдың өкпесінде, ішкі мүшелерінде, танаудың кілегей қабықтарында және терісінің әр жерінде өзіндік (маңқалық) түйіндердің, іріңді күлдіреуіктің, абсцесстің щығуымен, олар ыдырағанда орындарында іріңді ойық жара пайда болуымен сипатталатын созылмалы жұқпалы ауру. Кейде жіті түрде өтеді, саңқа ауруы адамға да жұғады. Бұл індетті қазақ халқы танау маңқасы, без маңқасы және көкірек маңқасы деп үш түрге бөледі. Ауру жедел және созылмалы болады.
Қоздырушысы және оның морфологиясы. Қоздырушысы Pseudomonas mallei патматериалдан жасалған жұғындыда шеттері жұмыр, жіңішке таяқша сияқты, ұқындығы 2-5 мкм, жуандығы 0, 5-0, 8 мкм. Жеке- жеке орналасады, кейде жұп түрінде. Микроб спора және капсула түзбейді.
Анилин бояуларымен бояуға болады, сілті қосса жақсы нәтиже береді. Мысалы: бояу мына құрамада: метилен көгінің қаныққан спиртті ерітіндісінің 3 бөлігінің, күйдіргіш натрийдің 0, 01% су ерітіндісінің бөлігі. Дайын жұғынды 3 минут боялады. Осы әдіспнее бояғанда маңқа таяқшаларының түйіршіктігі жақсы байқалады. Грам әдісімен боялмайды. Бөгде микроб жоқ, жарылмаған абсцесс, лимфа түйіндерінен және т. б. іріңді микроскопиялаудың балауда кейбір маңызы бар. Жарылған абсцессте және мұрын ағындысын микроскопиялау ештеңе бермейді.
Аурудың қоздырушысы 2-4% глицерин қосқан қарапайым қоректік орталарда өседі, аэробты. Глицеринді ЕПА екінші тәулікте шырышты жабысқан ақ- сұр түсті юолар- болмас қатпар пайда болады, бірте-бірте ол қоңырланады. Глицеринді ЕПС, тегіс бұдырланады, қабырғаға жанас сақина және шырышты қабықша, кейіннен ақ-сұр тұнба түзеді.
Төзімділігі. Pseudomanas mallei сыртқы ортада төзімсіз. 80°С температаурада қыздыру 5 минутта, күн сәулесі 24 сағатта, қарын сөлі 30 минутта қоздырушыны жояды. Су ішінде және шіріп жатқан материалда микроб 10 тәуліктің ішінде өледі, кепкен танау бөліндісінде 7-15 күн, несепте 4 сағат тірі қалады. 1% күйдіргіш натрий ерітіндісі, 2% фенол, 5% ерітіндісі қырып тастайды.
Патогендігі. Маңқаға тақ тұяқтылар бейім: жылқы, есек, қашыр. Маңқамен жыртқыштарда (арыстан, жолбарыс, ілбісін, сілеусін, аю) ауырады.
ТМД елдерінде маңқа жойылған, бірақта көрші Азия елдерінде бұл ауру әлі де орын алады, демек оның біздің территориямызға ену қаупі бар. Аурудың негізгі көзі ауру малдар, әсіресе ауру белгісі білінбейтін созылмалы түрімен ауыратындары. Негізінен жұқпалысы тыныс жолдарынан бөлінгендер, мұрындарынан аққандар және жұлынынан қалған терідегі ойық жаралар. Осы бөлінгендер мал азығын, суатты, мал күтіміне қажет құрал- саймандарды сау малдарды залалдайды. Ауру негізінен ас қорыту аппараттары, сиректеу терісі арқылы жұғады. Тікелей жанасу арқылы да (түшкіру, пысқыру, осқыру, ойықшы жараны жалау) жұғуы ықтимал, бірақ ол сирек, демек ауру малды бірден жояды. Ал созылмалы ауратындары байқаусыз қалып, ауру таратушылар болмақ.
Аурудың белгілері. Бұл індетті қазақ халқы танау маңқасы, без маңқасы және көкірек маңқасы деп үш түрге бөледі. Ауру жедел және созылмалы болады. Жасырын кезеңі 3 - 21 күн. Ауырған жылқының ыстығы көтеріліп, қалтырайды, танауынан су ағып, көбіне астыңғы жақ сүйегінің астындағы түйіндер ісіп кетеді, кеңсірігінің кілегей қабықтары қызарып, ұсақ бөртпе жаралар пайда болады. Олардан қанды ірің ағады, лимфа түйіндері іріңдеп, жара жарылып кетеді. Ауру өршіген кезде кеңсірік желбезектері қанды іріңге толады. Терінің тесілген жерінен желім тәрізді ірің ағады, кейде аяқтары жуандап, ісіп кетеді. Созылмалы түрімен ауырған мал арықтап, жылдам болдырады. Маңқамен ауырған жылқының етін жеуге болмайды.

1-сурет. Маңқа ауруының қоздырушысы.
а)

Жылқының көзінен жас ағу
б)

Жылқының тері маңқасы
в)

Жақ сүйектің астыңғы түйіндері ісіп кеткен
2-а, б, в- сурет. Аурудың клиникалық белгілері.
Аурудың шығуы мен жұғуы. Маңқа қоздырғышы ауру мал денесінен сыртқа танау суы, қақырық арқылы, сондай-ақ терідегі уытты жара арқылы шығады. Маңқа ауру малдан сау малға өзара жанасқан кезде жұғады, сондай-ақ ол микроб қонған азық арқылы, суат, қора, ат әбзелі және күтім құрал-саймандары арқылы да жұғады. Ауру мал сау мал бірге болғанда азық арқылы, жайылымдға, суда, (жүген, тоқымумал күтетін заттар арқылы жұғады. Малға қарап жүрген адам өзі ауырып және ауру таратуы мүмкін.
Белгілеріне қарай маңқа - етше маңқасы, кеңсірік маңқасы және тері маңқасы болып, ал барысына қарай жіті және созылмалы маңқа болып бөлінеді. Инкубациялық период 2-3 аптадан, 2-3 айға созылуы мүмкін.
Аурудың 3 түрі кездеседі өкпе маңқасы, тері маңқасы, мұрын маңқасы.
Жіті түрдегі маңқа (бірнеше аптаға), ал созылмалы маңқа (бірнеше жылға) созылуы (ауруы) мүмкін өкпе маңқасы өте жай дамиды, білінбей ауырады, бірнеше ай немесе жыл бойы ауруы мүмкін, оның белгісі температурасы көтершіді, әсіресе кешке қарай көтеріледі жұмыс істеу қаблеті төмендейді ентігеді, арықтайды жөтеледі, өкпені тыңдағанда қырыл (хрип) естіледі. Осының бәрі малды нашарлатып, өлуге әкеледі.
Ж і т і м а ң қ а. Мұнымен көбінесе құлын ауырады. Ауру малдың температурасы қауырт көтеріліп, жүрек соғуы күрт әлсірейді, азыққа тәбеті тартпай, жалпы күйі ете-мөте нашарлайды.
Танаудың кілегейлі қабығы қызарып кетеді, желбезектің бір не екі жағында айналасы қызыл шеңбермен көмкерілген сарғыш-сұрғылт түсті қатты түйнекшелер пайда болады. Келесі күндері бұл түйнекшелер ыдырап езіледі де, бүршікті ткань шала жетілгендіктен олардың орнында ернеулері опырылып ирелендеген, әрбіреуінің түпкі жағы ет майы тәрізді, түсі тоң майдың түсі тәріздес көптеген сопақша жара пайда болады.
Жаралар бірімен-бірі ұласып, тез ұлғаяды да, көбіне кеңсірікті тесіп өтеді, танау-маңдай қуысын закымдайды. Танаудың іші қан араласқан сасық іріңге толады, екі танаудан, аққан ірің танаудың айналасына жиналып кебеді де, қабыршаққа айналады. Тынысы тарылып мал пысылдайды. Алқым бездері ұлғайған, адыр-бұдырлы келеді, сипалағанда ығыспайды.
Өкпесі зақымданса, мал демігеді, жөтеледі. Тыңдаған кезде кейде дымқыл сырыл естіледі. Кеудесін нұқып қаққанда өкпенің кейбір жерлерінен әдеттегі дүңкілдеген ашық дыбыстың орнына тықылдаған күңгірт дыбыс естіледі.
Терісі зақымданған жағдайда, ол көбіне малдың аяқтарында кездеседі, сөл бездері мен қан тамырлары қабынады.
Алғашқы кезде сөл бездері қап-қатты нығыз келеді, ал кейін жұмсарып ыдырайды, мұның нәтижесінде ойылған терең жаралар пайда болады, олардан май тәрізді жабысқақ сары сұйық зат ағып тұрады. Көптеген жағдайда дәнекер тканьінің шектен тыс қаулап өсуіне байланысты малдың зақымданған аяқтары дүмпиіп жуандайды (ұра) .
Клиникалық белгілері бірте-бірте жойылып, жіті маңқа созылмалы маңқаға айналады. Ауру асқынса, маңқаның зардабы бүкіл денеге тарайды, мұның салдарынан ауру мал әбден арып, өліп калады.
С о з ы л м а л ы м а ң қ а. Желбезекте түйнекшелер мен ойық жаралар пайда болады, алқым бездері сәл зақымданады, олар ұлғайып, нығыздалады және жөнді қозғалмайтын болып қалады. Қайсыбір жаралар жазылып кетуі мүмкін, олардың орнын дәнекер ткань басып, жұлдыз тәрізді тыртыққа айналады.
Маңқа ұзаққа созылса, өкпедегі зақымдану белгілері білінбейді, оларды мал өлгеннен кейін ғана көруге болады. Терінің сөл тамырлары сәл ғана зақымданады. Ауру бірнеше айға, тіпті талай жылға созылады, әлсін-әлсін асқынып отырады. Ұзақ уақыт бойы улану салдарынан мал әбден арықтап өледі.

3- сурет. Маңқамен ауырған жылқы.
4)

4-5- сурет. Pseudomonas mallei агардағы өсіндісі.
Өлекседегі патолого - анатомиялық өзгерістер . Желбезектің бір не екі жағынан маңқаға тән көптеген түйнекшелері мен ойық жаралар табылады. Алқым бездерінің көлемі ұлғайған, олар қабынған, олардың кей жерлерінде маңқа түйнекшелері байқалады.
Тері маңқасы болса, қабынған сөл тамырларын бойлай құрылысы өзгерген сөл түйіншелері орналасады. Оларды терең түп жағы ұшық жара басып кеткен. Ішкі органдардан және сөл бездерінен маңқа түйіндері мен одан да үлкен ошақтары табылады.
Ескі түйіндердің ортасынан әк шөгіндісі табылуы мүмкін. Өкпеден жалқаяқ жиналып қабыну, бронхоэктазия, каверна (қуыс), сондай-ақ көптеген маңқа түйіндері сияқты зақымдарды байқауға болады.
Осындай зақымдар бауырда, талақта, тіпті жүрек еттерінде де кездеседі, маңқа түйіндері мен паразит түйіндерін бір-бірінен ажырата білу керек. Соңғылар әдетте қос қабықты болып келеді, көбінесе олардың ішінен паразиттер табылады.


6- сурет. Өкпедегі әк шөгіндісі. Өкпеде жалқаяқ жиналулар.
Сауықтыру шаралары және індет ошағын жою. Инфекциялық аурумен күресуде басты шаралар үш бөліктен тұрады-
1) аурудың көзін жою
2) ауруды тарату жолдарын, жағдайларын жою
3) Малдың ауруға қарсы туралататын каблетін көтеру.
Айтылған шаралар профилактикалық (аурудың алдын алу, сактандыру) және лажсыз (ауру шыққан соң) болатын шаралардан тұрады.
Профилактикалық шараларға, малды азықтандыру, суғару, күту, бағу жатады. Малды күтүшілердің жеке гигиенасын сактау (арнайы киіммен камтамасыз ету, дизенфекциялық және жуушы дәрі - дәрмектер бөлу т. б) керек.
... жалғасы- Іс жүргізу
- Автоматтандыру, Техника
- Алғашқы әскери дайындық
- Астрономия
- Ауыл шаруашылығы
- Банк ісі
- Бизнесті бағалау
- Биология
- Бухгалтерлік іс
- Валеология
- Ветеринария
- География
- Геология, Геофизика, Геодезия
- Дін
- Ет, сүт, шарап өнімдері
- Жалпы тарих
- Жер кадастрі, Жылжымайтын мүлік
- Журналистика
- Информатика
- Кеден ісі
- Маркетинг
- Математика, Геометрия
- Медицина
- Мемлекеттік басқару
- Менеджмент
- Мұнай, Газ
- Мұрағат ісі
- Мәдениеттану
- ОБЖ (Основы безопасности жизнедеятельности)
- Педагогика
- Полиграфия
- Психология
- Салық
- Саясаттану
- Сақтандыру
- Сертификаттау, стандарттау
- Социология, Демография
- Спорт
- Статистика
- Тілтану, Филология
- Тарихи тұлғалар
- Тау-кен ісі
- Транспорт
- Туризм
- Физика
- Философия
- Халықаралық қатынастар
- Химия
- Экология, Қоршаған ортаны қорғау
- Экономика
- Экономикалық география
- Электротехника
- Қазақстан тарихы
- Қаржы
- Құрылыс
- Құқық, Криминалистика
- Әдебиет
- Өнер, музыка
- Өнеркәсіп, Өндіріс
Қазақ тілінде жазылған рефераттар, курстық жұмыстар, дипломдық жұмыстар бойынша біздің қор #1 болып табылады.



Ақпарат
Қосымша
Email: info@stud.kz